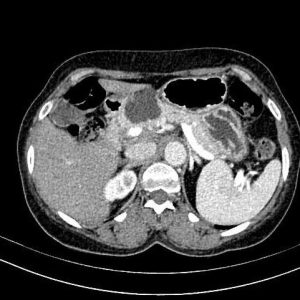
U tụy

TIÊU HOÁ
Hiển thị 481–500 của 1445 kết quảĐã sắp xếp theo mới nhất
-

Chảy máu túi mật
Lượt xem: 135» 08-11-2020 -

Bùn túi mật
Lượt xem: 128» 08-11-2020 -

Bùn túi mật
Lượt xem: 127» 08-11-2020 -

Bùn túi mật
Lượt xem: 145» 08-11-2020 -

Bùn túi mật
Lượt xem: 131» 08-11-2020 -

Viêm túi mật
Lượt xem: 157» 08-11-2020 -

Bùn túi mật
Lượt xem: 140» 08-11-2020 -

Bùn túi mật
Lượt xem: 124» 08-11-2020 -

Bùn túi mật
Lượt xem: 239» 08-11-2020 -

Bùn túi mật
Lượt xem: 163» 08-11-2020 -

U tụy
Lượt xem: 145» 07-11-2020 -

U tá tràng
Lượt xem: 302» 06-11-2020 -

Huyết khối TM cửa
Lượt xem: 311» 06-11-2020 -

Hamartoma đường mật
Lượt xem: 725» 06-11-2020 -

Hamartoma đường mật
Lượt xem: 310» 06-11-2020 -

Hamartoma đường mật
Lượt xem: 432» 06-11-2020 -

Hamartoma đường mật
Lượt xem: 273» 06-11-2020 -

Hamartoma đường mật
Lượt xem: 3258» 06-11-2020 -

Hamartoma đường mật
Lượt xem: 586» 06-11-2020 -

Nang ống mật chủ
Lượt xem: 172» 06-11-2020